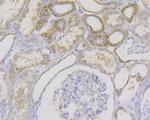
IL-17A Antibody in Immunohistochemistry (Paraffin) (IHC (P))

Search
Invitrogen
IL-17A Polyclonal Antibody
{{$productOrderCtrl.translations['antibody.pdp.commerceCard.promotion.promotions']}}
{{$productOrderCtrl.translations['antibody.pdp.commerceCard.promotion.viewpromo']}}
{{$productOrderCtrl.translations['antibody.pdp.commerceCard.promotion.promocode']}}: {{promo.promoCode}} {{promo.promoTitle}} {{promo.promoDescription}}. {{$productOrderCtrl.translations['antibody.pdp.commerceCard.promotion.learnmore']}}
图: 1 / 8
IL-17A Antibody (PA5-114345) in IHC (P)

Please note: We are reviewing Western blot images included in the antibody testing data in our catalog, including those provided by third parties. Unless expressly labeled or annotated as “raw-unedited”, Western blot images included in the antibody testing data in our catalog may have been edited, optimized or otherwise adjusted for presentation.
产品信息
PA5-114345
种属反应
已发表种属
宿主/亚型
分类
类型
抗原
偶联物
形式
浓度
规格
纯化类型
保存液
内含物
保存条件
运输条件
RRID
靶标信息
Interleukin-17A (IL-17A, CTLA-8) is a CD4+ T cell-derived cytokine that promotes inflammatory responses in cell lines and is elevated in rheumatoid arthritis, asthma, multiple sclerosis, psoriasis, and transplant rejection. IL-17A is a 32 kDa long, disulfide-linked homodimer consisting of 136 amino acids that is a member of a six-species family of proteins (IL-17A-17F) and signals through the IL-17 receptor (IL-17R/CDw217). High levels of IL-17A homodimer are produced by activated peripheral blood CD4+ T-cells, and IL-17A also enhances expression of the intracellular adhesion molecule-1 (ICAM-1) in human fibroblasts. In particular, human IL-17A also stimulates epithelial, endothelial, or fibroblastic cells to secrete IL-6, IL-8, G-CSF, and PGE2. In the presence of human IL-17A, fibroblasts can sustain the proliferation of CD34+ hematopoietic progenitors and induce maturation into neutrophils. Mouse, rat, and human IL-17A can induce IL-6 secretion in mouse stromal cells, indicating that all homologs can recognize the mouse receptor. IL-17A regulates the activities of NF-kappa B and mitogen-activated protein kinases, stimulates the expression of IL-6 and cyclooxygenase-2 (PTGS2/COX-2), and enhances the production of nitric oxide (NO).
仅用于科研。不用于诊断过程。未经明确授权不得转售。
生物信息学
蛋白别名: CTLA-8; Cytotoxic T-lymphocyte-associated antigen 8; il 17; IL-17; ILN; Interleukin; interleukin 17; Interleukin 17 (cytotoxic T-lymphocyte-associated serine esterase 8); Interleukin-17A; Interleukin17A; R-IL-17-A
基因别名: CTLA-8; CTLA8; IL-17; IL-17A; IL17; IL17A
UniProt ID: (Mouse) Q62386
Entrez Gene ID: (Mouse) 16171, (Rat) 301289




